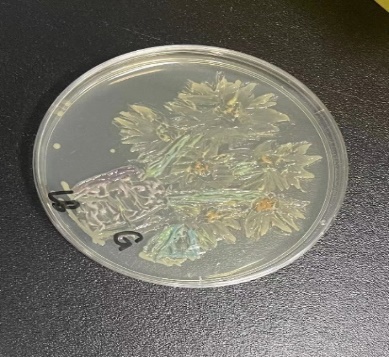
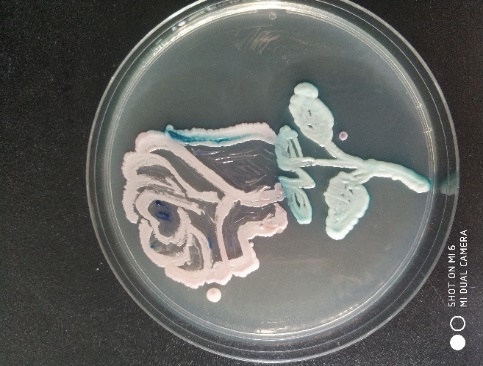

“以微生物为颜料,用培养基当画板”,在9-10月举办的江苏省微生物学会培养皿艺术大赛中,我院有五位438211班的同学在高大庆老师的指导和带领下积极参与,尽情展现自己的艺术天赋。在创作过程中,几位同学团结一致,通力合作,前后查阅了数十种适合接种的菌种,再结合东南大学几个较为突出的元素,如大礼堂、校徽等,经历了若干次失败与重创,精益求精,最终创作出了4幅作品。其中《大礼堂》获得了二等奖,其余三幅作品均获得三等奖的好成绩。
通过这次比赛,五位同学再次熟悉并巩固了微生物知识,对于各类微生物培养特性的理解又加深了不少。同时,在合作创作的过程中,他们感受到了思维与艺术的碰撞。从微观的微生物接种到宏观的颜色、线条、纹理的展现,5位同学充分显示了自己的想象力和才华,也彰显了微生物的魅力。


二等奖作品《大礼堂》


三等奖作品《江淮之水,恩泽于民》

三等奖作品 《向日葵》

三等奖作品 《阳光玫瑰》

 搜索
搜索